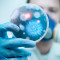

читайте у блозі
Скалічені діти. Як поліомієліт загрожує Україні
Через пандемію коронавірусу в Україні різко впав рівень щеплення дітей, зокрема і від поліо
14 Січня 2022 11:02
Навколо світу за один день: у Луцьку можна побачити масштабний проєкт із гігантськими 3D-символами світу
Сьогодні 13:10
Сьогодні 13:10
Без їжі та води: на Одещині учасники писали НМТ майже 13 годин через повітряні тривоги
Сьогодні 12:54
Сьогодні 12:54
На Волині екологи перевіряють можливе забруднення річки Стир
Сьогодні 12:03
Сьогодні 12:03